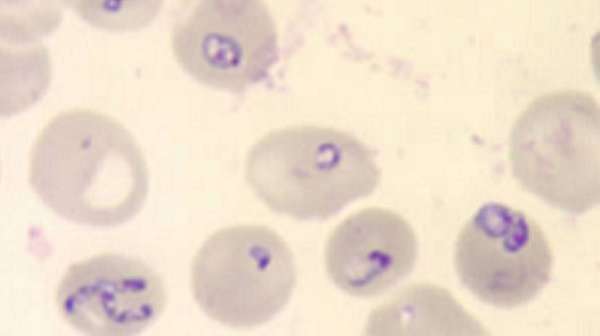
Babesiosis

La babesiosis es una infección intraeritrocitaria infrecuente de origen parasitario, causada por protozoos del género Babesia, los cuales invaden y destruyen los glóbulos rojos del hospedador. Esta enfermedad es transmitida principalmente por garrapatas del género Ixodes, que actúan como vectores biológicos del parásito durante su ciclo de vida. En los Estados Unidos, la especie más comúnmente implicada es Babesia microti, un protozoo que también mantiene un reservorio natural en diversos mamíferos silvestres, particularmente en roedores.
La distribución geográfica de la babesiosis en Estados Unidos se concentra mayoritariamente en regiones costeras del noreste, como Nueva Inglaterra, y en algunas zonas del medio oeste superior, siguiendo el patrón ecológico del vector Ixodes scapularis, también conocido como garrapata de patas negras. Esta especie de garrapata es, además, responsable de la transmisión de otras enfermedades zoonóticas relevantes, como la enfermedad de Lyme y la anaplasmosis, lo que contribuye a un solapamiento epidemiológico entre estas infecciones. En los últimos años, se ha observado una tendencia al aumento de la incidencia de babesiosis en ciertas regiones, posiblemente relacionada con cambios ecológicos, climáticos y demográficos que afectan la distribución de los vectores y sus hospedadores.
En otras partes del mundo, particularmente en Europa y Asia, la babesiosis humana suele ser causada por Babesia divergens y especies filogenéticamente relacionadas, que muestran un tropismo similar por los eritrocitos y suelen transmitirse por otras especies de Ixodes. En el oeste de los Estados Unidos también se han documentado, aunque con poca frecuencia, casos de babesiosis asociados a organismos similares a Babesia, cuyo impacto epidemiológico aún no ha sido completamente definido.
Además de la transmisión vectorial, la babesiosis puede propagarse a través de transfusiones de sangre contaminada, debido a que los donantes infectados pueden ser asintomáticos. Actualmente, los bancos de sangre no realizan pruebas de detección rutinarias para Babesia microti, lo cual representa un riesgo potencial para la seguridad transfusional. Estudios realizados en áreas endémicas han identificado que aproximadamente el 0,4 % de las muestras de sangre analizadas podrían contener el parásito, lo que subraya la necesidad de implementar medidas más rigurosas de vigilancia y control en estos entornos.
Manifestaciones clínicas
Los estudios seroepidemiológicos realizados en regiones endémicas de babesiosis indican que las infecciones asintomáticas son significativamente más comunes de lo que se pensaba, lo que sugiere una circulación silenciosa del parásito Babesia microti en la población general. Muchas personas expuestas al parásito desarrollan una respuesta inmunológica sin presentar manifestaciones clínicas evidentes, lo cual complica la detección y el control de la enfermedad, ya que los portadores asintomáticos pueden mantener parasitemia durante periodos prolongados sin buscar atención médica.
En los casos sintomáticos, la infección por Babesia microti suele desarrollarse tras un periodo de incubación de una a varias semanas después de la picadura de una garrapata infectada. El inicio de los síntomas es insidioso y con frecuencia los pacientes no recuerdan haber sido picados por una garrapata, lo cual dificulta el reconocimiento precoz del origen vectorial de la enfermedad. La presentación clínica típica se asemeja a un síndrome pseudogripal, con fiebre intermitente, sensación general de malestar, fatiga progresiva, cefalea, pérdida del apetito y dolor muscular difuso. En algunos casos, también se pueden observar náuseas, vómitos, dolor abdominal, artralgias, odinofagia, trastornos del estado de ánimo como depresión o labilidad emocional, así como signos hematológicos como anemia y trombocitopenia. A nivel bioquímico, pueden encontrarse elevaciones en las transaminasas hepáticas, y en ocasiones se detecta esplenomegalia como signo clínico adicional.
La parasitemia, es decir, la presencia de parásitos en la sangre periférica, suele ser evidente entre dos y cuatro semanas después de la exposición, y puede persistir durante varios meses o incluso años, independientemente de la presencia de síntomas. En la mayoría de los individuos inmunocompetentes, la infección se resuelve de forma espontánea y sin complicaciones graves. No obstante, existen grupos de riesgo en los que la babesiosis puede evolucionar hacia formas clínicas graves. Entre estos se encuentran las personas de edad avanzada y aquellas que han sido sometidas a esplenectomía, ya que el bazo desempeña un papel central en la eliminación de eritrocitos parasitados y en la modulación de la respuesta inmune.
En estos pacientes vulnerables, la babesiosis puede desencadenar complicaciones severas, entre ellas insuficiencia respiratoria, anemia hemolítica intensa, coagulación intravascular diseminada, insuficiencia cardíaca e insuficiencia renal aguda. Un estudio realizado en pacientes hospitalizados reveló una tasa de mortalidad del 6,5 %, lo que pone de manifiesto el potencial letal de la infección en ciertos contextos clínicos.
En Europa, los casos documentados de babesiosis por Babesia divergens han afectado predominantemente a pacientes esplenectomizados. Estas infecciones son especialmente agresivas, con una evolución clínica fulminante que incluye fiebre alta, anemia hemolítica grave, ictericia, hemoglobinuria e insuficiencia renal aguda. Las tasas de mortalidad en estos casos superan con frecuencia el 40 %, lo que refleja una virulencia significativamente mayor de esta especie en comparación con Babesia microti, así como la relevancia crítica del sistema inmunológico en el control de la infección.
Exámenes diagnósticos
El diagnóstico definitivo de babesiosis se establece mediante la identificación directa del parásito en el interior de los eritrocitos, utilizando extendidos sanguíneos teñidos con coloración de Giemsa. Esta técnica permite visualizar las formas intraeritrocitarias de Babesia, cuya morfología, aunque puede recordar superficialmente a la de los parásitos del género Plasmodium (causantes de la malaria), presenta características distintivas que permiten su diferenciación. Entre estas se incluyen la ausencia de pigmento hemozoico y la posibilidad de observar formas características en tetradas, conocidas como “formas en cruz de Malta”, que son patognomónicas de ciertas especies como Babesia microti.
No obstante, la detección mediante frotis sanguíneo puede ser complicada, especialmente en fases tempranas de la infección, debido a que la carga parasitaria suele ser muy baja. En muchos casos, menos del uno por ciento de los eritrocitos se encuentra parasitado al inicio de la enfermedad, lo que puede dificultar la observación directa del agente infeccioso. Por esta razón, a menudo se requieren múltiples muestras de sangre obtenidas en diferentes momentos para aumentar la probabilidad de detectar el parásito. Sin embargo, en infecciones más avanzadas o graves, la parasitemia puede superar el diez por ciento de los glóbulos rojos, lo que facilita su identificación microscópica.
Como método complementario o alternativo, la amplificación de ácido nucleico mediante reacción en cadena de la polimerasa representa una herramienta diagnóstica de alta sensibilidad y especificidad. La prueba de reacción en cadena de la polimerasa permite detectar incluso cantidades mínimas de material genético del parásito en la sangre, lo que resulta especialmente útil en infecciones con baja parasitemia o en pacientes con sintomatología atípica.
Además de estos métodos directos, existen pruebas serológicas que permiten evaluar la respuesta inmunológica del paciente frente a la infección. El Centro para el Control y la Prevención de Enfermedades ha desarrollado una prueba de anticuerpos por inmunofluorescencia indirecta dirigida contra Babesia microti. Esta prueba permite detectar anticuerpos específicos que comienzan a aparecer en la sangre aproximadamente entre dos y cuatro semanas después del inicio de los síntomas, y que pueden persistir durante varios meses. Un aumento cuádruple del título de anticuerpos entre la fase aguda y la fase de convalecencia confirma retrospectivamente la presencia de una infección reciente, lo cual es útil para el diagnóstico en pacientes que ya no presentan parasitemia detectable pero que tuvieron manifestaciones clínicas compatibles con babesiosis.
Tratamiento
La mayoría de los pacientes que desarrollan babesiosis presentan un cuadro clínico leve, caracterizado por síntomas inespecíficos de tipo gripal, y en muchos casos experimentan una recuperación espontánea sin necesidad de tratamiento farmacológico específico. Esta evolución benigna se observa con mayor frecuencia en personas inmunocompetentes y con una baja carga parasitaria, lo que sugiere que la respuesta inmune del hospedador juega un papel central en el control y resolución de la infección.
En los casos en que se considera necesario instaurar tratamiento —por ejemplo, en pacientes sintomáticos con enfermedad leve a moderada o en individuos con factores de riesgo—, el esquema terapéutico de primera elección consiste en una combinación de atovacuona y azitromicina administrada por vía oral durante un período de siete días. Específicamente, se recomienda atovacuona a razón de 750 miligramos cada doce horas, junto con azitromicina a una dosis diaria de 600 miligramos. Este régimen ha demostrado ser altamente eficaz en la erradicación del parásito y presenta un perfil de tolerabilidad favorable, con menos efectos adversos gastrointestinales y neurológicos que otras alternativas terapéuticas.
Una opción terapéutica alternativa, utilizada con mayor frecuencia en el pasado, combina quinina y clindamicina. En este caso, el tratamiento también se extiende por siete días, administrando quinina por vía oral a una dosis de 650 miligramos tres veces al día, junto con clindamicina, también por vía oral, a una dosis de 600 miligramos tres veces al día. Aunque este régimen tiene una eficacia comparable al de atovacuona con azitromicina, se asocia con una mayor incidencia de efectos secundarios como tinnitus, náuseas, mareos y diarrea, lo que puede limitar su uso en pacientes ambulatorios. No obstante, debido a su amplio historial de uso clínico, algunos expertos continúan recomendando esta combinación en contextos de enfermedad grave, especialmente cuando se requiere una intervención más agresiva.
En situaciones clínicas de especial gravedad, como en pacientes esplenectomizados o inmunodeprimidos con una parasitemia elevada —particularmente cuando esta supera el 10 % de los eritrocitos circulantes—, se ha recurrido con éxito al procedimiento de recambio de eritrocitos mediante transfusión terapéutica. Esta técnica, conocida como exanguinotransfusión o recambio eritrocitario, tiene como objetivo reducir rápidamente la carga parasitaria y mejorar la oxigenación tisular, al mismo tiempo que se eliminan mediadores inflamatorios y productos de la hemólisis. Este enfoque puede ser decisivo para evitar complicaciones como insuficiencia multiorgánica, y se reserva para casos en los que el tratamiento farmacológico aislado podría no ser suficiente para controlar la progresión de la enfermedad.

Fuente y lecturas recomendadas:
- Waked R et al. Human babesiosis. Infect Dis Clin North Am. 2022;36:655. [PMID: 36116841].